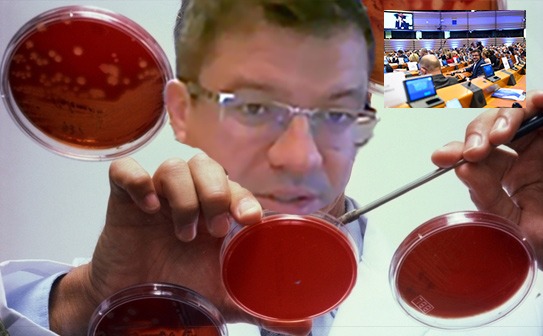

În țara unde bursele elevilor sunt legendă urbană, iar laptele pruncilor se dă cu porția, Don Costelo — voievodul dosarelor penale — ne reprezintă, cu fruntea sus și brățara strălucind, la Adunarea Euroregiunilor. Nu ca acuzat, cum ar zice bunul-simț, ci ca demn reprezentant al unei Românii tot mai obișnuită cu rușinea.
Trai neneacă! În timp ce elevii își caută bursa cu lupa și mamele vânează reduceri la lapte praf, Don Costelo defilează în costume scumpe și zâmbește larg în plenul european. La gleznă, în loc de brățară de localizare — cum ar cere firescul justiției — poartă una de protocol, bine lustruită și asortată la microfon.
Se zice că excursia asta diplomatică n-a venit degeaba. E, chipurile, o mică răsplată pentru “reabilitarea” unui spital de copii, unde singurele entități care s-au dezvoltat au fost… bacteriile. Crescute cu grijă, ca-n laborator, prin grija unor lucrări făcute din pix și fonduri dispărute pe drumul dezinfectantului.
Spitalul acela, unde zece bebeluși au fost îmbolnăviți sau chiar uciși de microorganisme mai bine întreținute decât pacienții, e acum tăcut. Sau nu chiar…
Într-un colț uitat de salon, două bacterii chicotesc într-o cultură Petri uitată de ani:
— Psst, vezi cine a apărut pe ecran? E șefu’ nostru!
— Don Costelo? Dumnezeule bacterian, încă-i liber?!
— Liber și promovat! Acum ne reprezintă la Bruxelles!
— Păi normal, cu ce-am realizat împreună… un mic genocid microscopic!
— Eu zic să-i trimitem o scrisoare de mulțumire. Scrisă cu puroi, să nu uite de unde a plecat!
Și uite-așa, între o poză oficială și-un cocktail de protocol, România mai bifează o victorie: inculpatul de onoare zâmbește larg, iar justiția se face că nu vede.
Cu brățara pe piciorul greșit.





















































